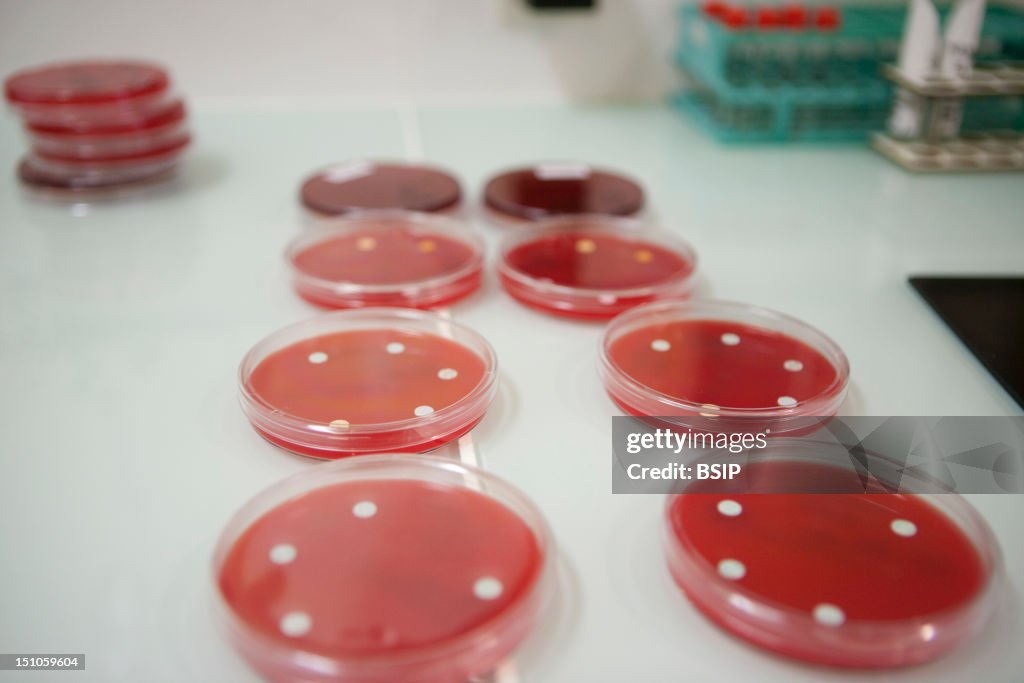

Antimicrob. Susceptibility Test
Croix Saint Simon Hospital, Paris, France. Laboratory. Antimicrobial Susceptibility Test. The Sensibility To Different Antibiotics Of The Bacterium Infecting The Patient Is Tested With An Antibiogram. Therefore, The Bacterial Culture Is Seeded On A Petri Dish. Each Disc Is Impregnated With A Different Antibiotic ; If The Antibiotic Is Effective, It Will Inhibit The Bacterial Growth. We Screen Depending On The Inhibition Diameter, Antibiotics That Are Active Sensible Bacterium Or Non Active Resistant Bacterium. (Photo By BSIP/UIG Via Getty Images)
PURCHASE A LICENCE
How can I use this image?
AED 1,300.00
AED
Getty ImagesAntimicrob. Susceptibility Test, News Photo
Antimicrob. Susceptibility Test Get premium, high resolution news photos at Getty ImagesProduct #:151059604

AED1,850AED600
Getty Images
In stockPlease note: images depicting historical events may contain themes, or have descriptions, that do not reflect current understanding. They are provided in a historical context. Learn more.
DETAILS
Restrictions:
Contact your local office for all commercial or promotional uses.
Credit:
Editorial #:
151059604
Collection:
Universal Images Group
Date created:
21 October, 2009
Upload date:
Licence type:
Release info:
Not released. More information
Source:
Universal Images Group Editorial
Object name:
941_04_6987309
Max file size:
4992 x 3328 px (42.27 x 28.18 cm) - 300 dpi - 3 MB